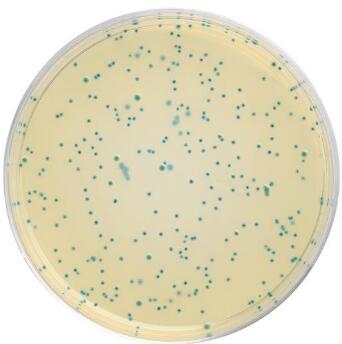
凝乳拟杆菌

万千商家帮你免费找货
0 人在求购买到急需产品
- 详细信息
- 技术资料
- 库存:
60
- 英文名:
Paenibacillus curdlanolyticus
- 保质期:
详见说明书
- 供应商:
上海谷研
- 保存条件:
低温冷藏
- 规格:
详见说明书

接头蛋白Gab 2抗体 别 名 GAB 2; Grb 2 associated binder 2; GRB 2 associated binding protein 2; Grb2 associated binder 2; GRB2 associated binder 2 pp100; GRB2 associated binding protein 2; Growth factor receptor bound protein 2 associated protein 2; KIAA0571; p97; PH domain containing adaptor molecule p97; pp100; Alternative namesGRB2 associated binder 2 pp100.
谷胱甘肽硫转移酶pi基因抗体 别 名 Glutathione S-Transferase pi; GST-Pi; DFN7; Gst-P1; FAEES3; Fatty Acid Ethyl Ester Synthase III; Glutathione S Transferase Pi; GST3; GSTP1; GST pi; PI; GSTP1_HUMAN.
谷氨酰胺合成酶/谷氨酸氨连接酶抗体 别 名 GLNA; GLNS; GLUL; Gl Syn; glutamate-ammonia ligase; glutamine synthetase; GS; PIG 43; PIG 59; PIG43; PIG59; Proliferation inducing protein 43.
| 产品名称 | 凝乳拟杆菌 |
| 培养条件 | 30°C |
| 编号 | GOY-5199 |
中文名称: 凝乳拟杆菌
CIP104575标准菌株基本信息
保藏机构:CIP
菌种名称:CIP104575, CIP 104575
英文名称:Paenibacillus curdlanolyticus
中文名称凝乳拟杆菌
存储人:Kanzawa et al.
来源历史:<< LMG << IFO << T.Harada Kobe Women's Univ.
其他保藏中心编号:TCC 51898 ; CIP 104575 ; DSM 10247 ; Harada YK 9 ; IFO 15724 ; LMG 17529
分离来源:土壤
菌种特性
备注:
培养条件:30°C
生物安全等级:1
氧气需求:需氧
培养基:TSB培养基:3
NUTRIENT AGAR (DIFCO 0001)
Beef extract 3.0 g
Peptone 5.0 g
Agar 15.0 g
Distilled water 1.0 L
Adjust pH to 7.0.
模式菌株:是
公司介绍:
上海谷研实业有限公司GuYan Biotech Co.,Ltd.(Shanghai,China)专业经营生科研化试剂、分析试剂 , 代理 许多国际先进水平的高科技产品,包括分子生物学、细胞生物学、免疫学、诊断等多个研究及应用领域。我们努力将欧美专业生产厂家的具有国际先进水平的产品推荐给各类研究人员;另一方面也非常重视自主产品研究和开发,推出了一系列具有竞争力的产品和服务。同时国家对于生物行业的发展给予了极大的重视,更多地侧重于科研的投入。公司客户遍布大学、研究所、医院、卫生防疫、商品检验检疫、制药公司、生物技术公司和食品工业等单位。公司的服务和业务 在同行获得一致好评。其立足于生命科学领域,全力打造高品质生物科技产品链和技术服务链,也具备丰富的管理经验,同时我们建立了集技术支持、售后服务等多方位的服务体系。我们有激情、有理想,更有责任感,是您科研道路上值得信赖的伙伴。公司的理念是:以诚信为本,努力打造优质品牌,为您提供全方位的售中、售后服务。

Corin蛋白(CRN)elisa英文名称:CRN ELISA Kit,英文缩写:CRN,产品别名:Corin蛋白(CRN)ELISA,Corin蛋白(CRN)产品保存:2~8℃、有效期6个月。
Axis抑制蛋白2(AXIN2)elisa英文名称:AXIN2 ELISA Kit,英文缩写:AXIN2,产品别名:Axis抑制蛋白2(AXIN2)ELISA,Axis抑制蛋白2(AXIN2)产品保存:2~8℃、有效期6个月。
CD109分子(CD109)elisa英文名称:CD109 ELISA Kit,英文缩写:CD109,产品别名:CD109分子(CD109)ELISA,CD109分子(CD109)产品保存:2~8℃、有效期6个月。
AMPA离子能谷氨酸受体1(GRIA1)elisa英文名称:GRIA1 ELISA Kit,英文缩写:GRIA1,产品别名:AMPA离子能谷氨酸受体1(GRIA1)ELISA,AMPA离子能谷氨酸受体1(GRIA1)产品保存:2~8℃、有效期6个月。
Ⅱ型胶原(COL2)elisa英文名称:COL2 ELISA Kit,英文缩写:COL2,产品别名:Ⅱ型胶原(COL2)ELISA,Ⅱ型胶原(COL2)产品保存:2~8℃、有效期6个月。
5-基四氢叶酸高半胱氨酸基转移酶(MTR)elisa英文名称:MTR ELISA Kit,英文缩写:MTR,产品别名:5-基四氢叶酸高半胱氨酸基转移酶(MTR)ELISA,5-基四氢叶酸高半胱氨酸基转移酶(MTR)产品保存:2~8℃、有效期6个月。
1,5-脱水葡萄糖醇(1,5-AG)elisa英文名称:1,5-AG ELISA Kit,英文缩写:1,5-AG,产品别名:1,5-脱水葡萄糖醇(1,5-AG)ELISA,1,5-脱水葡萄糖醇(1,5-AG)产品保存:2~8℃、有效期6个月。
转录因子SOX-5(SOX5)elisa英文名称:SOX5 ELISA Kit,英文缩写:SOX5,产品别名:转录因子SOX-5(SOX5)ELISA,转录因子SOX-5(SOX5)产品保存:2~8℃、有效期6个月。
肿瘤坏死因子受体相关因子1(TRAF1)elisa英文名称:TRAF1 ELISA Kit,英文缩写:TRAF1,产品别名:肿瘤坏死因子受体相关因子1(TRAF1)ELISA,肿瘤坏死因子受体相关因子1(TRAF1)产品保存:2~8℃、有效期6个月。
脂多糖(LPS)elisa英文名称:LPS ELISA Kit,英文缩写:LPS,产品别名:脂多糖(LPS)ELISA,脂多糖(LPS)产品保存:2~8℃、有效期6个月。
载脂蛋白B100(apo-B100)elisa英文名称:apo-B100 ELISA Kit,英文缩写:apo-B100,产品别名:载脂蛋白B100(apo-B100)ELISA,载脂蛋白B100(apo-B100)产品保存:2~8℃、有效期6个月。
N-α-酰转移酶38(NαA38)
N-α-酰转移酶40(NαA40)
N-α-酰转移酶50(NαA50)
N-酰α-D-氨基葡萄糖苷酶(NAGLU)
N-酰β-D-氨基葡萄糖苷酶(NAGase)
N-酰β-D-氨基葡萄糖苷酶(NAGase)
KCTC15143, KCTC15143英文名称:Rhodopseudomonas pentothenatexigens,五齿红假单胞菌菌种又名: 中文名称:五齿红假单胞菌菌种代号:KCTC 15143; NBRC 108862; JA575分离:土壤来源历史:<< KCTC
KCTC23310, KCTC23310英文名称:Gemmobacter tilapiae,芽生菌菌种又名: 中文名称:芽生菌菌种代号:KCTC 23310分离:淡水来源历史:<< NCMU, W. M. Chen, Ruye-53 (Catellibacterium tilapiae)
KCTC3967, KCTC3967英文名称:Bacillus horikoshii,芽孢杆菌菌种又名: 中文名称:芽孢杆菌菌种代号:LMG 17946; ATCC 700161; CIP 105300; DSM 8719; KCTC 3967分离:土壤来源历史:<< LMG << DSMZ << H. Outtrup, Novo Nordisk A/S; JP 277. PN 121.
KCTC12791, KCTC12791英文名称:Inhella inkyongensis菌种又名: 中文名称: 菌种代号:CCUG 54308; KCTC 12791; IMCC 1713; NBRC 103252; DSM 23958分离:富营养化人工淡水塘来源历史:<< CCUG << KCTC << IMCC
KCTC23862, KCTC23862英文名称:Tepidimonas fonticaldi菌种又名: 中文名称: 菌种代号:KCTC 23862; LMG 26746分离:泉水来源历史:<< NKMU, W. M. Chen, AT-A2 (Tepidimonas caldifontis)
风险提示:丁香通仅作为第三方平台,为商家信息发布提供平台空间。用户咨询产品时请注意保护个人信息及财产安全,合理判断,谨慎选购商品,商家和用户对交易行为负责。对于医疗器械类产品,请先查证核实企业经营资质和医疗器械产品注册证情况。
 技术资料
技术资料暂无技术资料 索取技术资料
凝乳拟杆菌
询价